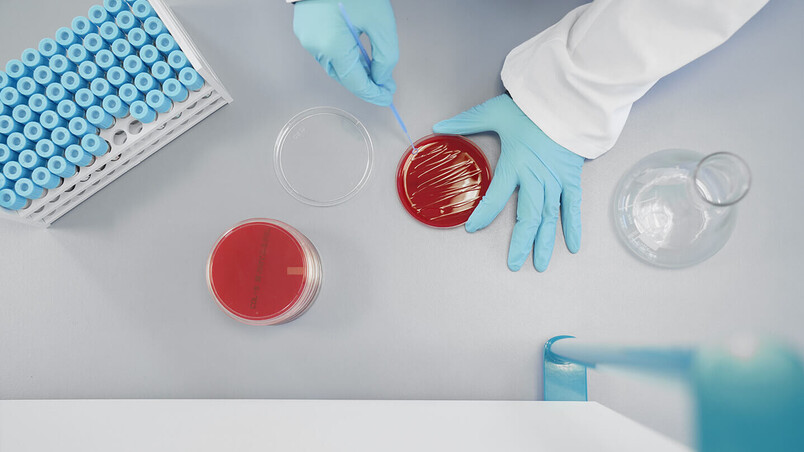

Facts & Figures
Cat.No.: 62000
710 x 825 x 970 mm
Dimensions (WxDxH)
IVDR
Model
150 l
Internal volume
82 l
Validated usable space
2 (Standard + 1 HTS)
Number Of Provided Trays
0.045 kWh/h
Energy consumption
Efficient use of valuable space
Environmentally friendly, economical and well designed.
HettCube incubators relieve your budget and protect the environment, as well as offer your cultures the best possible growth conditions. The size of the HettCube 200 makes it ideal for all types clinical lab applications.
Advantages
Areas of applications
Clinical microbiology, clinical monitoring
Clinical specimen taken from patients or obtained in the course of hygienic monitoring of hospitals are incubated to identify bacteria, fungi, and yeast.

Facilities
- Microbiological labs
Hospital labs
The right accessories for this incubator
Compactly designed for the HettCube 200 and HettCube 200 R, offering maximum functionality.
- Two drawers for efficient and organized storage
- Secure lockable design for added safety
- Smooth-rolling casters with locks for stability and mobility
- Dimensions (W x D x H): 770 x 800 x 550 mm
Cat.No.: 60010

- Made of stainless steel
- With standard rails
- Max. load: 50 kg
Cat.No.: 60001

The Hettich Telescope System allows the internal space of the HettCube to be used optimally. Telescopic rails make it easy to work and permit use of the entire surface area. Even samples that are way in the back can be easily reached.
- Made of stainless steel
- Telescopic pull-out up to 70 %
- Max. load: 40 kg
Cat.No.: 60031

The Hettich Telescope System allows the internal space of the HettCube to be used optimally. Telescopic rails make it easy to work and permit use of the entire surface area. Even samples that are way in the back can be easily reached.
- Made of stainless steel
- Telescopic pull-out up to 70 %
- Max. load: 40 kg
Cat.No.: 60024

The Hettich Telescope System allows the internal space of the HettCube to be used optimally. Telescopic rails make it easy to work and permit use of the entire surface area. Even samples that are way in the back can be easily reached.
- Made of stainless steel
- Telescopic pull-out up to 70 %
- Max. load: 40 kg
Cat.No.: 60025

The Hettich Telescope System allows the internal space of the HettCube to be used optimally. Telescopic rails make it easy to work and permit use of the entire surface area. Even samples that are way in the back can be easily reached.
- Made of stainless steel
- Telescopic pull-out up to 70 %
- Max. load: 40 kg
Cat.No.: 60026

The Petri dish rack allows large numbers of cultures to be processed quickly and economically. The rack has been specially developed to make the handling of Petri dishes easier.
- Made of stainless steel and autoclavable
- Telescopic pull-out up to 70 %
- Max. load: 90 Petri dishes (Ø 90 mm)
Optimum use of valuable space:
Up to two racks and thus 180 Petri dishes are possible per pair of rails. Fully loading the HettCube 200 with the racks results in a capacity of 360 Petri dishes.
Note: For covering the entire slide-in level, the additional selection of Cat.No. 60040 is necessary.
Cat.No.: 60038 (for HettCube 200 | 200 R)

The Petri dish rack allows large numbers of cultures to be processed quickly and economically. The rack has been specially developed to make the handling of Petri dishes easier.
- Made of stainless steel and autoclavable
- Max. load: 90 Petri dishes (Ø 90 mm)
Optimum use of valuable space:
Up to two racks and thus 180 Petri dishes are possible per pair of rails. Fully loading the HettCube 200 with the racks results in a capacity of 360 Petri dishes.
Note: For covering the entire slide-in level, the additional selection of Cat.No. 60040 is necessary.
Cat.No.: 60039 (for HettCube 200 | 200 R)

- Ideally suited for the Loewenstein Method
- Inclination angle: 5°
- Made of stainless steel and autoclavable
Telescopic pull-out up to 70 %
Optimum use of valuable space:
The max. load per rack is 81 tubes (Ø 15-20 mm, length 160 mm). Fully loading the HettCubes with the racks results in the following capacities:
| HettCube 200 | HettCube 400 | HettCube 600 |
|---|---|---|
| 3 racks = 243 tubes | 8 racks = 648 tubes | 14 racks = 1134 tubes |
Cat.No.: 60036

- Ideally suited for the Loewenstein Method
- Inclination angle: 5°
Made of stainless steel and autoclavable
Optimum use of valuable space:
The max. load per rack is 81 tubes (Ø 15-20 mm, length 160 mm). Fully loading the HettCubes with the racks results in the following capacities:
| HettCube 200 | HettCube 400 | HettCube 600 |
|---|---|---|
| 6 racks = 486 tubes | 16 racks = 1296 tubes | 29 racks = 2349 tubes |
Cat.No.: 60037

- Ideally suited for the Loewenstein Method
- Inclination angle: 5°
Made of stainless steel and autoclavable
Optimum use of valuable space:
The max. load per rack is 81 tubes (Ø 15-20 mm, length 160 mm). Fully loading the HettCubes with the racks results in the following capacities:
| HettCube 200 | HettCube 400 | HettCube 600 |
|---|---|---|
| 6 racks = 486 tubes | 16 racks = 1296 tubes | 29 racks = 2349 tubes |
Cat.No.: 60041

These flexible frames simplify handling, save time and enable the use of 16 tubes for different slant angles with 5° or 20°. The slant angle of the tubes can be very easily changed without the need for tools.
- Made of stainless steel and autoclavable
- Tube Ø: 15-20 mm
Tube lengths: 100-125 mm
Max. 3 racks possible per insertion shelf/drawer.
Cat.No.: 60027

These flexible frames simplify handling, save time and enable the use of 16 tubes for different slant angles with 5° or 20°. The slant angle of the tubes can be very easily changed without the need for tools.
- Made of stainless steel and autoclavable
- Tube Ø: 15-20 mm
Tube lengths: 126-170 mm
Max. 2 racks possible per insertion shelf/drawer.
Cat.No.: 60028


How can we help you?
Please tell us your request to find your personal contact.













